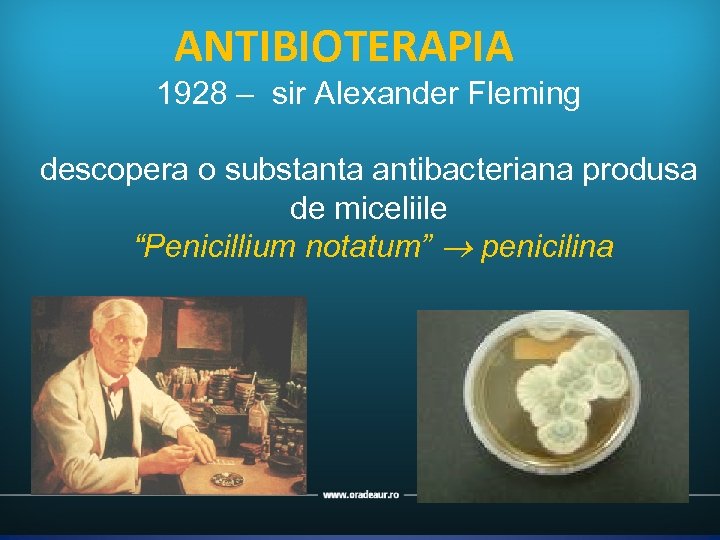

53b60ef997909dfe796902f2d4c4d6f2.ppt
- Количество слайдов: 55
 Program cofinantat din Fondul Social European prin Programul Operational Sectorial Dezvoltarea Resurselor Umane 2007 -2013 INVESTESTE IN OAMENI! Infectii posoperatorii si posttraumatice: cauze si tratament Cristina Brinzeu Continutul acestui material nu reprezinta in mod obligatoriu pozitia oficiala a Uniunii Europene sau a Guvernului Romaniei
Program cofinantat din Fondul Social European prin Programul Operational Sectorial Dezvoltarea Resurselor Umane 2007 -2013 INVESTESTE IN OAMENI! Infectii posoperatorii si posttraumatice: cauze si tratament Cristina Brinzeu Continutul acestui material nu reprezinta in mod obligatoriu pozitia oficiala a Uniunii Europene sau a Guvernului Romaniei
 “Cheia. . . antibioterapiei raţionale este identificarea acelor pacienţi care necesită tratament antibiotic şi optimizarea terapiei lor pentru a ajunge rapid la vindecarea clincă şi bacteriologică” J. Garau Clin Microb Infect 2006
“Cheia. . . antibioterapiei raţionale este identificarea acelor pacienţi care necesită tratament antibiotic şi optimizarea terapiei lor pentru a ajunge rapid la vindecarea clincă şi bacteriologică” J. Garau Clin Microb Infect 2006
 Identificarea infectiilor Cui “Cheia. . . ? dam antibiotic ATB (definiţie): medicament antibacterian. . . antibioterapiei raţionale este identificarea acelor pacienţi care necesită tratament Infecţii Tratament antibiotic şi optimizarea terapiei lor pentru a ajunge Profilaxie rapid la vindecarea clincă şi Risc de infecţie bacteriologică” NU J. Garau Clin Microb Infect 2006 Gradul de colonizare
Identificarea infectiilor Cui “Cheia. . . ? dam antibiotic ATB (definiţie): medicament antibacterian. . . antibioterapiei raţionale este identificarea acelor pacienţi care necesită tratament Infecţii Tratament antibiotic şi optimizarea terapiei lor pentru a ajunge Profilaxie rapid la vindecarea clincă şi Risc de infecţie bacteriologică” NU J. Garau Clin Microb Infect 2006 Gradul de colonizare
 ANTIBIOPROFILAXIA “Cheia. . . • Administarea antibioticului inainteaidentificarea. . . antibioterapiei raţionale este contaminarii bacteriene potentiale in timpul interventiei chirurgicale • acelor pacienţi care necesită tratament Problema deşi optimizarea terapiei lor pentru a antibiotic sanatate publica USA-infectii 500000/an-(2 -20% )Franta-38% din decesele ajunge rapid la vindecarea clincă şi pacientilor chirurgicali bacteriologică” • Costurile interventiei cresc intre 3800 -11000$/caz J. Garau Clin Microb Infect 2006
ANTIBIOPROFILAXIA “Cheia. . . • Administarea antibioticului inainteaidentificarea. . . antibioterapiei raţionale este contaminarii bacteriene potentiale in timpul interventiei chirurgicale • acelor pacienţi care necesită tratament Problema deşi optimizarea terapiei lor pentru a antibiotic sanatate publica USA-infectii 500000/an-(2 -20% )Franta-38% din decesele ajunge rapid la vindecarea clincă şi pacientilor chirurgicali bacteriologică” • Costurile interventiei cresc intre 3800 -11000$/caz J. Garau Clin Microb Infect 2006
 “Cheia. . . De ce profilaxia? . . . antibioterapiei raţionale este identificarea acelor pacienţi care necesită tratament • reducerea incidentei infectiei chirurgicale a antibiotic şi optimizarea terapiei lor pentru IC ajunge rapid la vindecarea • utilizarea antibioticelor “adecvat” clincă şi bacteriologică” • reducerea efectelor asupra florei pacientului mecanismelor de aparare, efecte adverse J. Garau Clin Microb Infect 2006
“Cheia. . . De ce profilaxia? . . . antibioterapiei raţionale este identificarea acelor pacienţi care necesită tratament • reducerea incidentei infectiei chirurgicale a antibiotic şi optimizarea terapiei lor pentru IC ajunge rapid la vindecarea • utilizarea antibioticelor “adecvat” clincă şi bacteriologică” • reducerea efectelor asupra florei pacientului mecanismelor de aparare, efecte adverse J. Garau Clin Microb Infect 2006
 Antibioprofilaxia Baker FG Mai 2007 Meta-analiza 6 RCT: 1729 pacienti Profilaxia reduce la jumatate frecventa meningitelor post operatorii dupa craniotomie OR 0, 43 (95% CI 0, 2 -092; p= 0. 03) Riscul de infectie cu germeni multirezistenti ramane!
Antibioprofilaxia Baker FG Mai 2007 Meta-analiza 6 RCT: 1729 pacienti Profilaxia reduce la jumatate frecventa meningitelor post operatorii dupa craniotomie OR 0, 43 (95% CI 0, 2 -092; p= 0. 03) Riscul de infectie cu germeni multirezistenti ramane!
 Antibioprofilaxia Inutila si daunatoare! Este necesara: se face pana la externarea pacientului Este utila si lipsita de riscuri daca respecta anumite reguli Elaborarea principiilor- ALTEMEIER 1955
Antibioprofilaxia Inutila si daunatoare! Este necesara: se face pana la externarea pacientului Este utila si lipsita de riscuri daca respecta anumite reguli Elaborarea principiilor- ALTEMEIER 1955
 Clasificarea Altemeier Fără ATB Cu ATB Chirurgie curată 1 -5% <1% Chirurgie curată contaminată Chirurgie contaminată 5 -15% < 7% Chirurgie “murdară“ >30% > 15% < 15%
Clasificarea Altemeier Fără ATB Cu ATB Chirurgie curată 1 -5% <1% Chirurgie curată contaminată Chirurgie contaminată 5 -15% < 7% Chirurgie “murdară“ >30% > 15% < 15%
 Chirurgia curata • Chirurgia electiva • Fara traumatism, fara inflamatie • Fara deschiderea viscerelor cavitare sau contaminate • Fara abateri de la asepsie Craniotomie, chirurgia vertebro-spinala, carotidei, . . .
Chirurgia curata • Chirurgia electiva • Fara traumatism, fara inflamatie • Fara deschiderea viscerelor cavitare sau contaminate • Fara abateri de la asepsie Craniotomie, chirurgia vertebro-spinala, carotidei, . . .
 Chirurgia curata contaminata • Chirurgie electiva si de urgenta • Deschiderea unui organ cavitar minim contaminat: sinusuri • Drenaj mecanic simplu: drenaj ventriculo peritoneal • Abatere minima de la asepsie
Chirurgia curata contaminata • Chirurgie electiva si de urgenta • Deschiderea unui organ cavitar minim contaminat: sinusuri • Drenaj mecanic simplu: drenaj ventriculo peritoneal • Abatere minima de la asepsie
 Chirurgia contaminata • • Traumatism deschis <4 h Chirurgie in prezenta infectiei Contaminare bacteriana prin continut infectat Inflamatie acuta fara puroi • Abatere majora de la asepsie • Fracturi deschise, Plaga cranio-cerebrala Antibioterapie
Chirurgia contaminata • • Traumatism deschis <4 h Chirurgie in prezenta infectiei Contaminare bacteriana prin continut infectat Inflamatie acuta fara puroi • Abatere majora de la asepsie • Fracturi deschise, Plaga cranio-cerebrala Antibioterapie
 Antibioticoprofilaxia 2006 5 RCT și 17 non-RCT 2168 pacients 208 randomised ( analize separate) Nu este demonstrata eficacitatea profilaxiei antibiotice la pacientii cu fracturi craniene si fistula LCR
Antibioticoprofilaxia 2006 5 RCT și 17 non-RCT 2168 pacients 208 randomised ( analize separate) Nu este demonstrata eficacitatea profilaxiei antibiotice la pacientii cu fracturi craniene si fistula LCR
 Antibioprofilaxia Operative Sepsis in Neurosurgery: A Method of Classifying Surgical Cases Narotam Pradeep K. , et al. Martie 1994 Tucson, Arizona
Antibioprofilaxia Operative Sepsis in Neurosurgery: A Method of Classifying Surgical Cases Narotam Pradeep K. , et al. Martie 1994 Tucson, Arizona
 Chirurgia “murdara” • • Traumatism deschis > 4 h Tesuturi devitalizate Tesuturi infectate : meningo-encefalite, abcese Contaminare cu corpi straini Antibioterapie!
Chirurgia “murdara” • • Traumatism deschis > 4 h Tesuturi devitalizate Tesuturi infectate : meningo-encefalite, abcese Contaminare cu corpi straini Antibioterapie!
 Factori de risc Legati de pacient Legati de procedura Legati de germeni
Factori de risc Legati de pacient Legati de procedura Legati de germeni
 PACIENT • • • Status imunologic si nutritional Diabet zaharat, dializa cronica Corticoterapie, transplantati Spitalizare indelungata Fumat
PACIENT • • • Status imunologic si nutritional Diabet zaharat, dializa cronica Corticoterapie, transplantati Spitalizare indelungata Fumat
 Procedura chirurgicala • • Prezenta de corp strain Gradul de contaminare Gradul de traumatizare tisulara Organul tinta
Procedura chirurgicala • • Prezenta de corp strain Gradul de contaminare Gradul de traumatizare tisulara Organul tinta
 Germenii Patogen Frecventa % Stafilococ auriu Staf. coagulazo negativ Enterococi 20% 14% 12% • Virulenta Escherichia colli 8% • Susceptibilitate si rezistenta • Bacterii vizate: Stafilococus aureus, S. epidermidis, Psudomonas aeruginosa 8% bacili Gram negativi 7% Enterobacter spp. Candida albicans 3% Streptococi de grup D 2% Bacteroides fragilis 2%
Germenii Patogen Frecventa % Stafilococ auriu Staf. coagulazo negativ Enterococi 20% 14% 12% • Virulenta Escherichia colli 8% • Susceptibilitate si rezistenta • Bacterii vizate: Stafilococus aureus, S. epidermidis, Psudomonas aeruginosa 8% bacili Gram negativi 7% Enterobacter spp. Candida albicans 3% Streptococi de grup D 2% Bacteroides fragilis 2%
 Clasificare Infectiilor craniene • Infectii superficiale- pielea si t. subcutanat • Infectii profunde-fascie, muschi • Infectii de organ/cavitate in primele 30 de zile; in primul an pentru implant
Clasificare Infectiilor craniene • Infectii superficiale- pielea si t. subcutanat • Infectii profunde-fascie, muschi • Infectii de organ/cavitate in primele 30 de zile; in primul an pentru implant
 Antibioticul pentru profilaxie • Sa fie activ impotriva germenilor vizati • Sa fie bactericid • Sa penetreze in tesutul interesat, cu o farmacocinetica adaptata tipului de chirurgie • Sa nu induca rezistenta bacteriana SFAR – Recommandations pour la pratique de l’antibioprophylaxie en chirurgie
Antibioticul pentru profilaxie • Sa fie activ impotriva germenilor vizati • Sa fie bactericid • Sa penetreze in tesutul interesat, cu o farmacocinetica adaptata tipului de chirurgie • Sa nu induca rezistenta bacteriana SFAR – Recommandations pour la pratique de l’antibioprophylaxie en chirurgie
 Antibioticul pentru profilaxie • Sa nu modifice ecosistemul • Sa aiba toleranta buna , efecte adverse minime • Sa nu fie folosit in terapie • Sa fie ieftin SFAR – Recommandations pour la pratique de l’antibioprophylaxie en chirurgie. Actualisation 1999; 2003 Antibioprophilaxie en chirurgie a l, hospital. Saint Louis, Mars 2006
Antibioticul pentru profilaxie • Sa nu modifice ecosistemul • Sa aiba toleranta buna , efecte adverse minime • Sa nu fie folosit in terapie • Sa fie ieftin SFAR – Recommandations pour la pratique de l’antibioprophylaxie en chirurgie. Actualisation 1999; 2003 Antibioprophilaxie en chirurgie a l, hospital. Saint Louis, Mars 2006
 Momentul si durata administrarii • Atb prezent in tesuturi in toata perioada cu risc, nivelul sanguin >CMI ! • O doza cu 30 – 60 min inainte de incizie • Administrare intravenoasa • Interventia >3 -4 ore, se repeta doza initiala • Risc crescut : 24 – 48 h Scottish Intercollegiate Guidelines Network. Antibiotic prophylaxis in surgery. A national clinical guideline. July 2008
Momentul si durata administrarii • Atb prezent in tesuturi in toata perioada cu risc, nivelul sanguin >CMI ! • O doza cu 30 – 60 min inainte de incizie • Administrare intravenoasa • Interventia >3 -4 ore, se repeta doza initiala • Risc crescut : 24 – 48 h Scottish Intercollegiate Guidelines Network. Antibiotic prophylaxis in surgery. A national clinical guideline. July 2008
 Recomandari Profilaxia SSI : • • ghiduri proprii in fiecare spital administrare < 24 h o dosa start inainte de incizie adresarea germenilor frecventi Staphyllococcus aureus S. epidermidis In special dupa craniotomie Enterobacteriaceae dupa drenaje Anaerobes mai ales dupa plagi cranio – cerebrale
Recomandari Profilaxia SSI : • • ghiduri proprii in fiecare spital administrare < 24 h o dosa start inainte de incizie adresarea germenilor frecventi Staphyllococcus aureus S. epidermidis In special dupa craniotomie Enterobacteriaceae dupa drenaje Anaerobes mai ales dupa plagi cranio – cerebrale
 Medicamentele utilizate • • • Medicamente pentru profilaxie: Cefazolin Cefuroxim 1 doza in inductie Metronidazol Vancomicina Clindamicina Se poate prelungi pana la 48 de ore.
Medicamentele utilizate • • • Medicamente pentru profilaxie: Cefazolin Cefuroxim 1 doza in inductie Metronidazol Vancomicina Clindamicina Se poate prelungi pana la 48 de ore.

 Antibioprofilaxia in Neurochirurgie • Chirurgie curata: craniotomie, hernie de disc CEFAZOLIN • Chirurgie curata contaminata: CEFUROXIM deschiderea sinusurilor, drenaj ventriculo-peritonal • Chirurgia contaminata: LCR-infectat AMPICILINA • Chirurgia murdara: plagi infectate, abcese SULBACTAM Germenii vizati: S. aureus, Stafilococul epidermidis, anaerobi IN CAZ DE ALERGIE -Vancomicina
Antibioprofilaxia in Neurochirurgie • Chirurgie curata: craniotomie, hernie de disc CEFAZOLIN • Chirurgie curata contaminata: CEFUROXIM deschiderea sinusurilor, drenaj ventriculo-peritonal • Chirurgia contaminata: LCR-infectat AMPICILINA • Chirurgia murdara: plagi infectate, abcese SULBACTAM Germenii vizati: S. aureus, Stafilococul epidermidis, anaerobi IN CAZ DE ALERGIE -Vancomicina
 Antibioprofilaxia endocarditei bacteriene controversata inca • pacient cu risc: valvulari, cardiopatii congenitale • se alege profilaxia endocarditei Ampicilina/sulbactam Amoxicilina/clavulanat Clindamicina
Antibioprofilaxia endocarditei bacteriene controversata inca • pacient cu risc: valvulari, cardiopatii congenitale • se alege profilaxia endocarditei Ampicilina/sulbactam Amoxicilina/clavulanat Clindamicina
 Controlul infectiilor chirurgicale • • Dezinfectia si asepsia adecvate Conditii optime in blocul operator Hemostaza adecvata Scurtarea duratei interventiei
Controlul infectiilor chirurgicale • • Dezinfectia si asepsia adecvate Conditii optime in blocul operator Hemostaza adecvata Scurtarea duratei interventiei
 Masuri complementare • oxigenoterapia perioperatorie • controlul glicemiei • prevenire hipotermiei Furnary R et al. Continuous intravenous insulin infusion reduces the incidence of deep sternal wound infection in diabetic patients after cardiac surgical procedures. Ann Thorac Surg 1999 Kurz al. N Engl J Med. 1996
Masuri complementare • oxigenoterapia perioperatorie • controlul glicemiei • prevenire hipotermiei Furnary R et al. Continuous intravenous insulin infusion reduces the incidence of deep sternal wound infection in diabetic patients after cardiac surgical procedures. Ann Thorac Surg 1999 Kurz al. N Engl J Med. 1996
 Ghidurile sunt necesare Sanford Guide 2009 US National Surgical Infection Preventions Project Protocoles 2007. Departement d’Anesthesie – Reanimation. Hopital de Bicetre Antibioprophilaxie en chirurgie a l, hopital Saint Luis 2006 Scottish intercolegiate Guidelines Network.
Ghidurile sunt necesare Sanford Guide 2009 US National Surgical Infection Preventions Project Protocoles 2007. Departement d’Anesthesie – Reanimation. Hopital de Bicetre Antibioprophilaxie en chirurgie a l, hopital Saint Luis 2006 Scottish intercolegiate Guidelines Network.
 Antibioticoprofilaxia -ghiduri. Surgical intervention SFAR 1999 revised in 2004 SANFORD 2005 Duration Craniotomy Cefazolin 2 g Cefazoline 2 g Single dose Cross sinuses Cefazoline 2 g Augmentin 1, 2 g Single dose Spinal surgery Cefazolin 2 g Oxaciline 2 g Cefazolin 2 g Single dose Cranio- cerebral wound Ampicillin/Sulbactam 1, 2 g/6 h No prophylaxis 48 h or 0 Shunt surgery Oxaciline 2 g Vancomicine 10 mg + GM 3 mg intraventricularlly Single dose Skull base fracture No prophylaxis 0
Antibioticoprofilaxia -ghiduri. Surgical intervention SFAR 1999 revised in 2004 SANFORD 2005 Duration Craniotomy Cefazolin 2 g Cefazoline 2 g Single dose Cross sinuses Cefazoline 2 g Augmentin 1, 2 g Single dose Spinal surgery Cefazolin 2 g Oxaciline 2 g Cefazolin 2 g Single dose Cranio- cerebral wound Ampicillin/Sulbactam 1, 2 g/6 h No prophylaxis 48 h or 0 Shunt surgery Oxaciline 2 g Vancomicine 10 mg + GM 3 mg intraventricularlly Single dose Skull base fracture No prophylaxis 0
 Aderenta la protocol Aderenta buna Complianta inca scazuta Administarea preoperatorie-71% Durata prelungita 35% Antibioprofilaxie adecvata 2/3 din pacienti ICAAC 2006 Mc. Carty. D. 2005 The National Surgical Quality Improvement Program
Aderenta la protocol Aderenta buna Complianta inca scazuta Administarea preoperatorie-71% Durata prelungita 35% Antibioprofilaxie adecvata 2/3 din pacienti ICAAC 2006 Mc. Carty. D. 2005 The National Surgical Quality Improvement Program
ANTIBIOTERAPIA 1928 – sir Alexander Fleming descopera o substanta antibacteriana produsa de miceliile “Penicillium notatum” penicilina
ANTIBIOTERAPIA 1928 – sir Alexander Fleming descopera o substanta antibacteriana produsa de miceliile “Penicillium notatum” penicilina
 INFECTIILE IN NCH • Infectii extracraniene • Infectii intracraniene • Alte infectii ale pacientului NCH
INFECTIILE IN NCH • Infectii extracraniene • Infectii intracraniene • Alte infectii ale pacientului NCH
 Infectii extracraniene • Infectii ale scalpului • Infectii subcutanate • Osteomielite pot fi : –Posttraumatice –Posttoperatorii
Infectii extracraniene • Infectii ale scalpului • Infectii subcutanate • Osteomielite pot fi : –Posttraumatice –Posttoperatorii
 Etiologia infectiilor extracraniene • Germeni din flora cutanata : ü S. aureus ü S. epidermidis ü Gram negative sau anaerobic -rar • Factori de risc : ü Plagi contaminate ü Fracturi comminutive ü Plagi nepenetrante punctiforme
Etiologia infectiilor extracraniene • Germeni din flora cutanata : ü S. aureus ü S. epidermidis ü Gram negative sau anaerobic -rar • Factori de risc : ü Plagi contaminate ü Fracturi comminutive ü Plagi nepenetrante punctiforme
 Etiologia infectiilor extracraniene
Etiologia infectiilor extracraniene
 Riscul de infectie Evaluating the risk of infection • Chirurgia-curata <1% • Implant x 2 • Chirurgia-curata cont. <5% • Chirurgia- contaminata 10% • Chirurgia murdara >15%
Riscul de infectie Evaluating the risk of infection • Chirurgia-curata <1% • Implant x 2 • Chirurgia-curata cont. <5% • Chirurgia- contaminata 10% • Chirurgia murdara >15%
 Infectii intracraniene • Meningite „secundare” • Posttraumatice • Postoperatorii -2% • Infectii asociate cu implanturi– drenaj ventriculoperitoneal • Ventriculite • Empieme subdurale si extradurale • Abcese cerebrale
Infectii intracraniene • Meningite „secundare” • Posttraumatice • Postoperatorii -2% • Infectii asociate cu implanturi– drenaj ventriculoperitoneal • Ventriculite • Empieme subdurale si extradurale • Abcese cerebrale
 Infectii ale SNC Menigita: INCLUDE: mengita simpla, meningoencefalita, ventriculita Abcese intracraniene: Empiem extra si subdural Abces cerebral Infectii primare: fara sursa evidenta Infectii secundare: postop / post TCC
Infectii ale SNC Menigita: INCLUDE: mengita simpla, meningoencefalita, ventriculita Abcese intracraniene: Empiem extra si subdural Abces cerebral Infectii primare: fara sursa evidenta Infectii secundare: postop / post TCC
 MENINGITE – diagnostic • Simptome similare cu meningita „primara” • Progresie-lenta • Diagnostic: • Markeri biologici in sange si LCR • Cultura LCR este importanta Mortalitate globala 30%
MENINGITE – diagnostic • Simptome similare cu meningita „primara” • Progresie-lenta • Diagnostic: • Markeri biologici in sange si LCR • Cultura LCR este importanta Mortalitate globala 30%
 MENINGITE- germeni Posttraumatice Postoperatorii Infectii de shunt Pneumococ 70 -85% Haemophilus influente 0 -15% Neisseria m. 0 -6% Stafilococi 0 -5% Germeni Gram 0 -5% Stafilococi MSSA Germeni Gram- 50 -60% 40 -50% Pneumococ 2 -8 % Haemophilus influente Stafilococi MRSA 65 -85% Germeni Gram 5 -20%
MENINGITE- germeni Posttraumatice Postoperatorii Infectii de shunt Pneumococ 70 -85% Haemophilus influente 0 -15% Neisseria m. 0 -6% Stafilococi 0 -5% Germeni Gram 0 -5% Stafilococi MSSA Germeni Gram- 50 -60% 40 -50% Pneumococ 2 -8 % Haemophilus influente Stafilococi MRSA 65 -85% Germeni Gram 5 -20%
 MENINGITE posttraumatice Incidenta TCC: 1 -2% Fracturi ale craniului: 10 -20% Fistule LCR : pana la 50% din rata infectiilor Factori de risc: Fistula LCR – durata fistulei Plagi cranio-cerebrale: ne sau penetrante Mortalitate : spre 10 %
MENINGITE posttraumatice Incidenta TCC: 1 -2% Fracturi ale craniului: 10 -20% Fistule LCR : pana la 50% din rata infectiilor Factori de risc: Fistula LCR – durata fistulei Plagi cranio-cerebrale: ne sau penetrante Mortalitate : spre 10 %
 MENINGITE asociate cu implanturi • In special in TCC: • Drenaj ventricular extern : intraventricular, intraparenchimatos • Incidenta: 0 -25% din drenajul ventricular ext. (in medie 10%) • Factori de risc: – Dutata mentinerii drenajului (>5 days) – Frecventa manipularii –Sangerarea intraventriculara
MENINGITE asociate cu implanturi • In special in TCC: • Drenaj ventricular extern : intraventricular, intraparenchimatos • Incidenta: 0 -25% din drenajul ventricular ext. (in medie 10%) • Factori de risc: – Dutata mentinerii drenajului (>5 days) – Frecventa manipularii –Sangerarea intraventriculara
 Managementul meningitei posttraumatice Terapia antibiotica empirica: Vancomicine 500 -750 mg/6 h plus Ceftriaxon 2 g /12 h Cetazidim 2 g/8 h Meropenem 2 g/8 h(Imipenem 500 -1000 mg/6 h) ANTIBIOGRAMA Profilaxia nu e dovedita Tratamentul chirurgical al fistulei
Managementul meningitei posttraumatice Terapia antibiotica empirica: Vancomicine 500 -750 mg/6 h plus Ceftriaxon 2 g /12 h Cetazidim 2 g/8 h Meropenem 2 g/8 h(Imipenem 500 -1000 mg/6 h) ANTIBIOGRAMA Profilaxia nu e dovedita Tratamentul chirurgical al fistulei
 PACIENT Streptococus pneumonie Haemofilus influente Streptococus agalactie Escherichia coli Neisseria meningitidis Listeria monocytogenes Cefalosporine III Vancomicina Ampicilina PEN. G
PACIENT Streptococus pneumonie Haemofilus influente Streptococus agalactie Escherichia coli Neisseria meningitidis Listeria monocytogenes Cefalosporine III Vancomicina Ampicilina PEN. G
 Infectii ale SNC-intracraniene Empiemul subdural si epidural Diagnostic: Examinare clinica si imagistica Microbiologie: – culturile din LCR sunt frecvent negative –culturile din aspirate sunt in 30% din cazuri negative – Anaerobii sunt frecventi
Infectii ale SNC-intracraniene Empiemul subdural si epidural Diagnostic: Examinare clinica si imagistica Microbiologie: – culturile din LCR sunt frecvent negative –culturile din aspirate sunt in 30% din cazuri negative – Anaerobii sunt frecventi
 Infectii ale SNC-intracraniene Abcesul cerebral Semne clinice : cefalee, febra, semne de focar Imagistica : sugestiva Hemocultura preoperatorie, daca sepsisul este prezent Prelevarea intraoperatorie : Anaerobes! Aerobes Fungi -flora mixta-greu de evidentiat-
Infectii ale SNC-intracraniene Abcesul cerebral Semne clinice : cefalee, febra, semne de focar Imagistica : sugestiva Hemocultura preoperatorie, daca sepsisul este prezent Prelevarea intraoperatorie : Anaerobes! Aerobes Fungi -flora mixta-greu de evidentiat-
 Infectii intracraniene-abces FACTORII DE RISC GERMENII INCRIMINATI Sinuzitele Streptococi aerobi/anaerobi Otite Bacteroides, Enterobacteriacee, Piocianic Staf. aureus, Staf. epidermidis Enterobacteriacee, Post NCH Post traumatic
Infectii intracraniene-abces FACTORII DE RISC GERMENII INCRIMINATI Sinuzitele Streptococi aerobi/anaerobi Otite Bacteroides, Enterobacteriacee, Piocianic Staf. aureus, Staf. epidermidis Enterobacteriacee, Post NCH Post traumatic
 Infectii intracraniene-abces 10 - 20% din abcesele cerebrale sunt posttraumatice Factori de risc : • Corpuri staine intracraniene : plagi penetrante • Plagi cranio- cerebrale ! Fragmente osoase • Plagi punctiforme • Fistule LCR • Post operatorii-fixarea haloului
Infectii intracraniene-abces 10 - 20% din abcesele cerebrale sunt posttraumatice Factori de risc : • Corpuri staine intracraniene : plagi penetrante • Plagi cranio- cerebrale ! Fragmente osoase • Plagi punctiforme • Fistule LCR • Post operatorii-fixarea haloului
 Infectii extracraniene Tratament chirurgical: A. Punctie si aspiratie B. Indepartare chirurgicala- excizie C. combinarea metodelor Vancomicine plus Cefepim Cetazidim Meropenem Imipenem • Terapie antibiotica empirica: • Terapie dupa cultura si antibiograma
Infectii extracraniene Tratament chirurgical: A. Punctie si aspiratie B. Indepartare chirurgicala- excizie C. combinarea metodelor Vancomicine plus Cefepim Cetazidim Meropenem Imipenem • Terapie antibiotica empirica: • Terapie dupa cultura si antibiograma
 Infectii extracraniene INFECTII PULMONARE Traheobronsita acuta Pneumonia comunitara acuta-PCA Pneumonia nozocomiala-PN INFECTIILE TRACTULUI URINAR Cistita Pielonefrita
Infectii extracraniene INFECTII PULMONARE Traheobronsita acuta Pneumonia comunitara acuta-PCA Pneumonia nozocomiala-PN INFECTIILE TRACTULUI URINAR Cistita Pielonefrita
 SEPSIS SIRS +INFECTIE=SEPSIS Sepsis + MSOF Insuficienta de organ ( respiratorie, = insuficienta multipla de organe renala. . ) Sepsis sever Hipoperfuzie tisulara : acidoza lactica, alterarea constientei, oligurie functionala Hipotensiune Soc alterarea multiorganica Sepsis sever + hipotensiune septic SIRS sau SEPSISULUI volemica datorata necorectata de refacerea Se poate corecta cu subst. vasoactive
SEPSIS SIRS +INFECTIE=SEPSIS Sepsis + MSOF Insuficienta de organ ( respiratorie, = insuficienta multipla de organe renala. . ) Sepsis sever Hipoperfuzie tisulara : acidoza lactica, alterarea constientei, oligurie functionala Hipotensiune Soc alterarea multiorganica Sepsis sever + hipotensiune septic SIRS sau SEPSISULUI volemica datorata necorectata de refacerea Se poate corecta cu subst. vasoactive
 Principii de baza • • Profilaxia „medicala” nedovedita Profilaxia prelungita selecteaza rezistenta Cultura si examen direct LCR pot fi utile HIC omoara (nu neaparat sepsisul) Infectie primara analiza HIV/TBC Penetrabilitatea conteaza Tratament prelungit
Principii de baza • • Profilaxia „medicala” nedovedita Profilaxia prelungita selecteaza rezistenta Cultura si examen direct LCR pot fi utile HIC omoara (nu neaparat sepsisul) Infectie primara analiza HIV/TBC Penetrabilitatea conteaza Tratament prelungit



